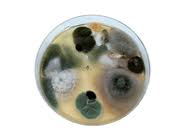

Are you one of many many that whenever you determined to visit your basement you notice that inexperienced or Black speck in your wall and also you stroll away? You ought to not as a consequence of if that Mold is greenish Black there is a good likelihood that it is Stachybotryschartarum or Stachybotrysatra. To most of the people it is called Black Mold or Toxic Mold. This can not only cause serious injury for a property however it can be very toxic and deadly. Go to Black Mold Abatement where you'll have the opportunity to read articles and watch high quality movies on Mold and other indoor associated topics.
When you find yourself dealing with any sort of mould this isn't one thing that you may flip your head or wipe the realm down with soap and water and it will go away. If you end up dealing with Black Mold Removal you have to know all the details because this dangerous fungus needs to be eliminated before later.
When you find yourself dealing with any sort of mould this isn't one thing that you may flip your head or wipe the realm down with soap and water and it will go away. If you end up dealing with Black Mold Removal you have to know all the details because this dangerous fungus needs to be eliminated before later.
Toxic Black Mold Symptoms can be severe and will get progressively worse over time. We know the aged, kids, pregnantwomanand those with immune system conditions are at greaterrisk, nonetheless it is not protected for anybody to dwell and breathe where Toxic Mold have been confirmed. Somesymptoms it's attainable you'll experience would come with complications, coughing, bronchial asthma, wheezing, bronchitis or rashes. If signs are left untreated as well as Mold Test Kits Iowa continue to develop this may lead to Mold Allergies. There have been over 100 different sorts of documented lung diseases associates with StachybotrysChartarum.
Moisture and humidity are the primary purpose mould will take up area and start to grow. Moisture causes mould to turn out to be extra vulnerable towards area. This relates to the reason you often see Black Mold affecting your bathroom, utility room or damp basement. Leaky pipes may grow to be a potential toxic hazard to the fungus and often these leaky pipes go unnoticed until you may have this musty scent that you simply cannot do away with or you see that small damp spot on your ceiling or wall.
![]() |
| Mold Test Kits Iowa |
Further places for Black mould to develop would come with wherever a flood has occurred. This could probably be from a serious flood from your storm, a bathroom that overflowed or that sump pump as part of your basement that malfunctioned. All are breeding grounds for Toxic Black Mold.
When you have purpose to consider that you've Toxic Mold you need to have a professional visit your property and do a whole Mold assessment and testing. These assessments will decide if you have Black Mold and if you happen to want Black Mold Abatement. This isn't something which you could deal with your self because it will probably cause you a lot problems. Black Mold Abatement needs to be carried out with a licensed skilled having the experience, coaching and tools to revive your property to its pre loss condition. When you might have profitable Mold Test Kits Iowa the odor can be gone, all spots removed plus your submit clearance test will show no signs of Black toxic mould